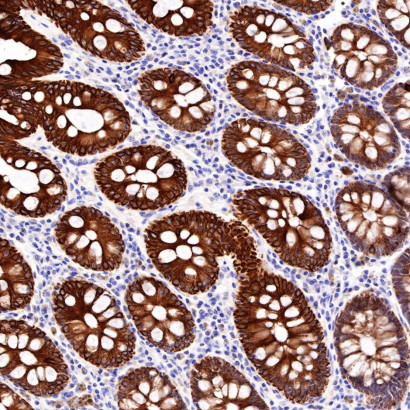

Home > News > The Key Role of CK-Pan Antibody in Cell Biology Research
The Key Role of CK-Pan Antibody in Cell Biology Research
- 1. Concept
Cytokeratin is a core member of the intermediate filament protein family and a fundamental structural component of epithelial cell cytoskeletons. CK-Pan antibody is a broad-spectrum detection tool that specifically recognizes conserved epitopes shared by multiple Type I (acidic) and Type II (basic) cytokeratins. It can simultaneously target subtypes such as CK1-CK8, CK10, CK14-CK16, and CK19, enabling efficient identification and localization of epithelial-derived cells. As an essential tool in cell biology, it supports research on epithelial cell differentiation, proliferation, and transformation, while playing a pivotal role in tumor pathology diagnosis and disease mechanism exploration.
2. Research Frontiers
2.1 Essential Tool in Cytoskeleton Research
CK-Pan antibody’s value in cytoskeleton research stems from its unique properties:
Broad-Spectrum Recognition: Binds common epitopes across multiple cytokeratin subtypes, ensuring high sensitivity even in complex biological samples.
Mechanism Insight: Cytokeratins form 10-nanometer intermediate filaments through heterodimerization, maintaining cellular mechanical integrity and participating in intracellular signaling. The antibody enables visualization of these structures, supporting studies on cytoskeleton dynamics.
Standardized Application: Serves as a gold standard for epithelial cell identification and epithelial-mesenchymal transition (EMT) monitoring in tissue engineering and cell biology research.
2.2 Advancing Tumor Pathology Diagnosis
CK-Pan antibody is a cornerstone of clinical tumor pathology:
Epithelial Origin Confirmation: Over 95% of carcinoma tissues express cytokeratins, making it a reliable marker for identifying epithelial-derived tumors and distinguishing adenocarcinoma, squamous cell carcinoma, and other subtypes.
Metastatic Cancer Diagnosis: Provides definitive evidence of epithelial origin for metastatic foci of unknown origin, aiding in primary tumor localization.
High Sensitivity: Detects minimal tumor cells (sensitivity of 0.01%), supporting tumor staging and prognosis evaluation.
Emerging Applications: Used in in vivo tumor tracing via molecular imaging to study metastasis mechanisms.
2.3 Key Application Points in Experimental Methodology
Optimal use of CK-Pan antibody requires attention to technical details:
Sample Preprocessing: Tissue fixation time should not exceed 24 hours to avoid epitope masking.
Antigen Retrieval: Heat-induced epitope retrieval with citrate buffer (pH6.0) significantly improves binding efficiency.
Antibody Dilution: Optimal working concentrations (1:50–1:200 for IHC) determined via checkerboard titration.
Quality Control: Includes positive controls (known positive tissues) and negative controls (negative serum substitution); specific staining appears as cytoplasmic brown-yellow granular deposits.
Special Sample Handling: For acid-treated or decalcified samples, extend antigen retrieval to 40 minutes and verify endogenous peroxidase quenching.
2.4 Emerging Applications in Disease Research
CK-Pan antibody’s application scope continues to expand with precision medicine advancements:Tumor Heterogeneity Research: Combined with subtype-specific keratin antibodies for refined tumor cell subtyping (e.g., breast cancer molecular subtyping with hormone receptor antibodies).
Circulating Tumor Cell (CTC) Detection: Synergistic use with epithelial cell adhesion molecule (EpCAM) antibodies improves CTC detection specificity and sensitivity.
Regenerative Medicine: Monitors epithelial cell differentiation and tissue maturity in engineered skin, cornea, and other epithelial tissues.
Novel Scientific Insights: Identifies cytokeratin expression in mesenchymal cells under specific microenvironments, challenging traditional epithelial marker paradigms.
2.5 Future Challenges and Development Opportunities
Despite widespread use, CK-Pan antibody faces ongoing development needs:
Quality Control Improvement: Stricter calibration systems and standardized procedures to reduce inter-batch variation.
Single-Cell Analysis Adaptation: Enhancing detection efficiency in minimal samples to support single-cell research.
AI Integration: Digital pathology analysis systems based on CK-Pan staining, reshaping traditional diagnostic models through artificial intelligence.
3. Research Significance
CK-Pan antibody addresses critical needs in cell biology and clinical research by enabling specific, broad-spectrum detection of epithelial cells and cytokeratins. It advances understanding of cytoskeleton function, epithelial cell biology, and tumor pathology, providing essential tools for basic research, disease diagnosis, and treatment planning. Its high sensitivity and specificity support early tumor detection and metastasis monitoring, improving patient outcomes. As a versatile reagent, it bridges basic science and clinical practice, driving progress in precision medicine, regenerative medicine, and oncology.
4. Related Mechanisms, Research Methods, and Product Applications
4.1 Mechanisms
CK-Pan antibody functions through two core mechanisms:
Epitope Recognition: Binds conserved epitopes across multiple cytokeratin subtypes, ensuring broad-spectrum detection while maintaining specificity for epithelial cells.
Signal Visualization: Conjugated dyes (e.g., Alexa Fluor® 488) or detection systems amplify signals, enabling visualization of low-abundance cytokeratins in cells and tissues.
4.2 Research Methods
Key methods leveraging CK-Pan antibody include:
Localization Techniques: Immunohistochemistry (IHC) for tissue sections, immunofluorescence (IF) for cells/tissues, and confocal microscopy for subcellular localization.
Quantification and Sorting: Western blot (WB) for protein expression analysis, flow cytometry for epithelial cell sorting, and CTC detection.
Multicolor Analysis: Integration into multicolor flow cytometry or imaging panels for complex biological system studies (e.g., tumor immune microenvironment analysis).
4.3 Product Applications
ANT BIO PTE. LTD.’s "S-RMab® Pan-Cytokeratin Recombinant Rabbit Monoclonal Antibody (Alexa Fluor® 488 Conjugate)" (Catalog No.: S0B0188) is a high-performance tool:
Core Advantages: High fluorescence quantum yield, excellent photostability, broad-spectrum keratin recognition, and low background; compatible with flow cytometers and confocal microscopes.
Key Application Scenarios:
* Epithelial cell identification and sorting from mixed cell populations.
* CTC enrichment and detection from peripheral blood.
* Tumor diagnosis and differential diagnosis of metastatic cancers.
* Multicolor flow/imaging panel construction for immune microenvironment or cell differentiation studies.
5. Brand Mission
ANT BIO PTE. LTD. is dedicated to empowering the global life science community with high-quality, innovative biological reagents and solutions. Leveraging advanced development platforms—including recombinant rabbit monoclonal antibody, recombinant mouse monoclonal antibody, rapid monoclonal antibody, and multi-system recombinant protein expression platforms (E.coli, CHO, HEK293, Insect Cells)—and adhering to rigorous international certifications (EU 98/79/EC, ISO9001, ISO13485), we strive to deliver reliable, performance-proven tools that accelerate scientific breakthroughs in cell biology, oncology, and regenerative medicine. Our commitment to quality and innovation aims to support researchers and clinicians in advancing human health through precise detection and cutting-edge life science research.
6. Related Product List
| Catalog No. | Product Name | Host |
| S0B1851 | CK-Pan Recombinant Rabbit mAb (Alexa Fluor® 647 Conjugate) (S-P001) |
Rabbit |
| S0B0188 | S-RMab® CK-Pan Recombinant Rabbit mAb (Alexa Fluor® 488 Conjugate) (S-P001) |
Rabbit |
| S0B2118 | S-RMab® CK-Pan Recombinant Rabbit mAb (SDT-P001) |
Rabbit |
| S0B2118P | S-RMab® CK-Pan Recombinant Rabbit mAb, PBS Only (SDT-P001) |
Rabbit |
| S0B0189 | CK-Pan Recombinant Rabbit mAb (Alexa Fluor® 594 Conjugate) (S-P001) |
Rabbit |
7. AI Disclaimer
This article is AI-compiled and interpreted based on the original work. All intellectual property (e.g., images, data) of the original publication shall belong to the journal and the research team. For any infringement, please contact us promptly and we will take immediate action.
ANT BIO PTE. LTD. – Empowering Scientific Breakthroughs
At ANTBIO, we are committed to advancing life science research through high-quality, reliable reagents and comprehensive solutions. Our specialized sub-brands (Absin, Starter, UA) cover a full spectrum of research needs, from general reagents and kits to antibodies and recombinant proteins. With a focus on innovation, quality, and customer-centricity, we strive to be your trusted partner in unlocking scientific mysteries and driving medical progress. Explore our product portfolio today and elevate your research to new heights.
Related News
- Thrombin Antibodies: How Aptamer Technology Revolutionizes Anticoagulation Treat 6/15/2026
- Monoclonal Antibodies: Achieving Precise Targeted Therapy Through Structural Opt 6/14/2026
- Monoclonal Antibodies: Achieving Precise Targeted Therapy Through Structural Opt 6/13/2026
- The Application and Validation of Serine/Threonine Phosphorylation Antibodies in 6/12/2026
- Hua Medicine Advances Glucose Homeostasis Platform at ADA 2026, Showcasing Dorza 6/12/2026
- How Do Phosphorylated Tau Antibodies Reveal the Mechanism of Protective Mutation 6/11/2026
- Everest Medicines Secures Exclusive License for Sumecigrel in Asia-Pacific, Expa 6/11/2026
- Merck Appoints New Heads of Discovery Solutions and Strategy & BD for Life Scien 6/9/2026
- AOP Health Targets Challenging Blood Cancers with First-In-Class Therapy 6/8/2026
- CD182 Antibody: Analyzing the Multiple Functions of CXCR2 Receptor in the Tumor 6/8/2026


